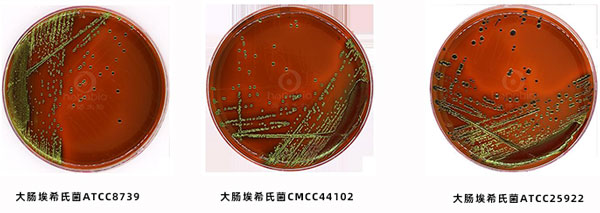

海博微信公众号
海博天猫旗舰店




一、产品用途:
用于弱选择性培养基,用于分离肠道致病菌,特别是大肠杆菌。
二、实验原理:
蛋白胨和牛肉浸粉作为基础营养物质提供细菌生长所需的氮源以及其他营养元素;乳糖作为可发酵的碳源;氯化钠能维持均衡的渗透压;曙红钠和亚甲基蓝同时作为抑制剂和指示剂,在酸性条件下结合形成黑色沉淀。曙红钠为酸性染料,亚甲基蓝为碱性染料,细菌分解乳糖产酸时,细菌带正电荷,可以与带负电的酸性染料结合即染上了曙红钠的颜色;如果细菌因产碱性物质较多,带负电荷时与带正电荷的碱性染料亚甲基蓝结合而使得菌落呈蓝色。细菌产酸量较大时,染料可析出结晶形成金属光泽;琼脂作为凝固剂。
三、培养基成分(g/L):
|
蛋白胨 |
10.0 |
|
牛肉浸粉 |
3.0 |
|
氯化钠 |
5.0 |
|
乳糖 |
10.0 |
|
亚甲蓝 |
0.065 |
|
曙红钠 |
0.4 |
|
琼脂 |
14.0 |
|
pH 7.2±0.2 25℃ |
|
四、试验方法:
称取本品 42.47g,加热溶解于1000ml纯化水中,121℃高压灭菌15 分钟,备用。
五、曙红亚甲基蓝琼脂培养基微生物灵敏度试验:
按标签用法制备培养基,接种以下质控菌株,放置30-35℃需氧培养18-24小时。
注:回收率计算时,用TSA琼脂做对照培养基。
|
质控菌株 |
菌株编号 |
接种量(CFU) |
参比或计数培养基 |
回收率 |
生长情况 |
其他特征 |
|
大肠埃希氏菌 |
CMCC44102 |
50-100 |
TSA |
≥70% |
+++ |
紫黑色菌落,有金属光泽 |
|
乙型副伤寒沙门菌 |
CMCC50094 |
50-100 |
TSA |
≥70% |
+++ |
无色半透明菌落 |
|
金黄色葡萄球菌 |
CMCC26003 |
100-1000 |
TSA |
/ |
- |
抑制 |
曙红亚甲基蓝琼脂培养基(EMB)上的细菌菌落特征:
相关产品:
注:本文属海博生物原创,未经允许不得转载。
上一篇:TOS培养基原理及介绍
